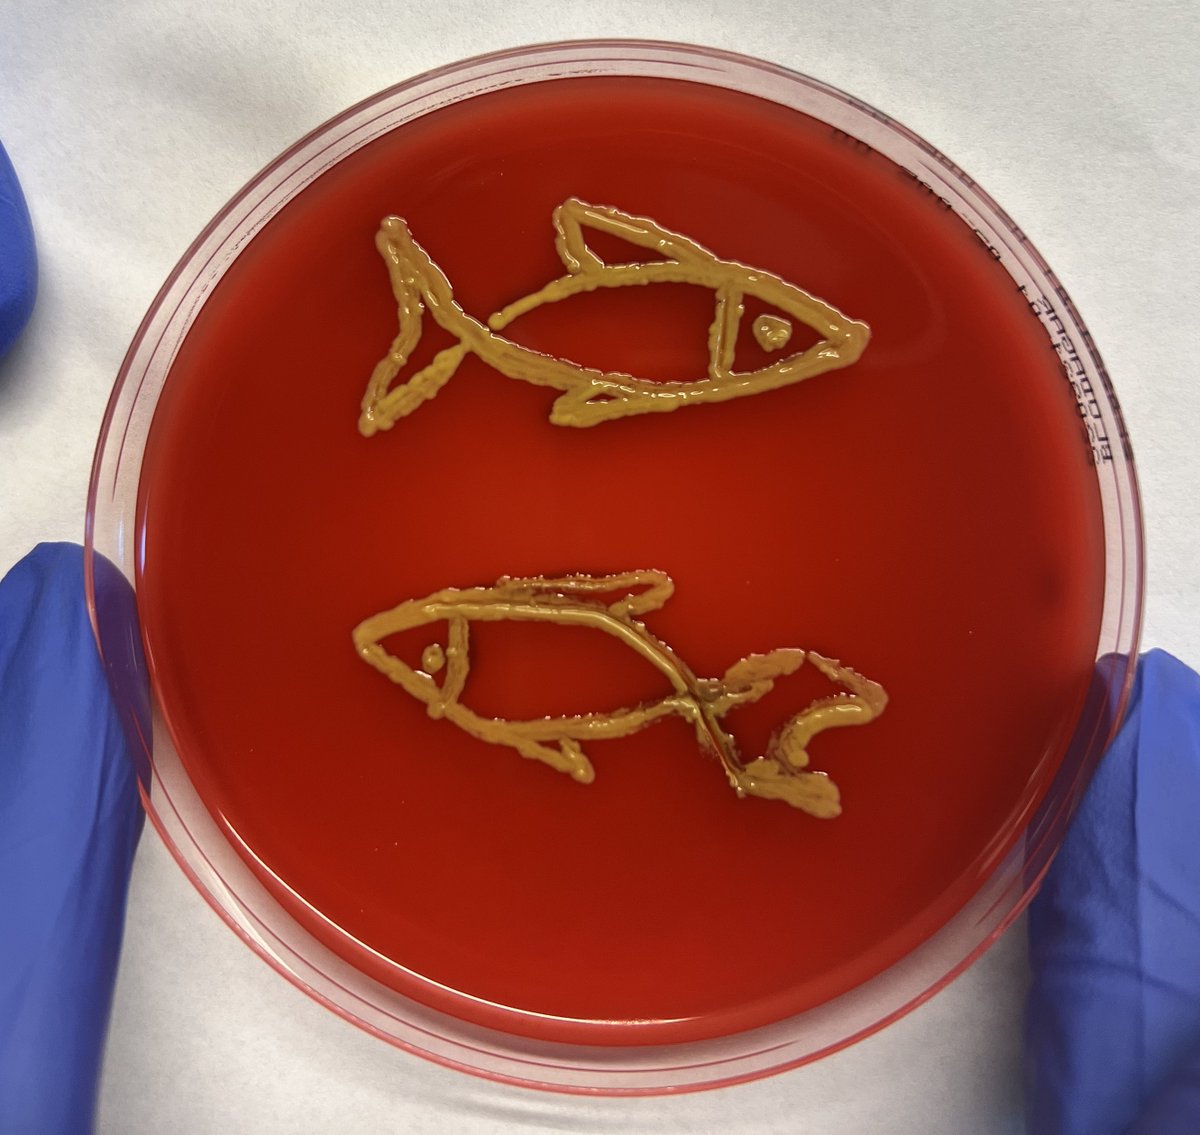
Prabhugouda Siriyappagouder tweet media

Prabhugouda Siriyappagouder
26 posts

Prabhugouda Siriyappagouder
@srgouda
Senior Engineer at FBA, Nord University @Norduniversitet 🇳🇴 Norway | Researcher in EpiMark Project | PhD in Aquatic Biosciences |
Bodø, Norway Katılım Temmuz 2014
214 Takip Edilen86 Takipçiler

Prabhugouda Siriyappagouder retweetledi

**Call for abstracts**
Send in before 30 Nov 2024!
OIKOS Norway 2025, the national conference of the Norwegian Ecological Society (NØF) will be held at Nord University in Bodø from 9 -12 Apr 2025. More information in our webpage nordicsocietyoikos.glueup.com/event/oikos-no…

English

…Times fly so fast, but I'm glad I'm still progressing.
6th anniversary of my PhD graduation 😊 @Norduniversitet @Jorges_Lab @JGV_immunology




English

New beginning and new adventures
Kickstart the new semester in Noatun's brand-new labs @Norduniversitet

English

@DrPorman It might be that your tapes or reagents because your upper markers don't look good unless you use El Ladeer again it is dimer
English

@PRupala @narendramodi @PMOIndia @Murugan_MoS @drsanjeevbalyan @BJP4India Hello Sir,
@PRupala
and
@FisheriesGoI Scientific name of Striped murrel should be changed to Channa striata and it is also wrongly depicted as the State fish of TN instead of Telangana and AP.
English
Prabhugouda Siriyappagouder retweetledi

This paper was conceived in 2020 and finally published after three years. A new user-friendly web platform for circRNA primer development. Congratulations to @GR_Rumon @JoostRaeymkrs @srgouda @JGV_immunology @Jorges_Lab
doi.org/10.1186/s12859…
English
Prabhugouda Siriyappagouder retweetledi

Check our latest ppr! It provides new insights into the #Covid19 pathogenesis using innocuous recombinant #SARS_CoV_2 S-derived peptides and validated in a #zebrafish model of #inflammation. @Norduniversitet @charliesilvaI @ZebrafishRock @eu_fish @ZFINmod nature.com/articles/s4159…
English
Prabhugouda Siriyappagouder retweetledi

I am excited to share our new paper that focuses on the role of #circRNA in #teleost #growth. Congratulations to @GR_Rumon @srgouda @JoostRaeymkrs @JGV_immunology @Jorges_Lab doi.org/10.1016/j.ygen…
English
Prabhugouda Siriyappagouder retweetledi

Our new preprint describes CircPrime web-based platform for #DNAprimer and thermocycling conditions design for #circularRNA identification with routine #PCR methods. Thanks to colleagues for their significant contribution: biorxiv.org/content/10.110…
English
Prabhugouda Siriyappagouder retweetledi

Our latest study reveals that polystyrene nanoplastics enhance the toxicological effects of DDE in #zebrafish
@Shubham87788523 @srgouda
sciencedirect.com/science/articl…
English
Prabhugouda Siriyappagouder retweetledi

The latest study from our group reveals the source-specific impact of β-glucans on the intestinal transcriptome of a #zebrafish model of hypercholesterolemia
frontiersin.org/article/10.338…
English

Toxicological effects of 6PPD and 6PPD quinone in zebrafish larvae sciencedirect.com/science/articl…
Română
Prabhugouda Siriyappagouder retweetledi

Excited to share the results of a successful collaboration between @Norduniversitet and @UMU showing that commensal yeast modulates metabolic pathways and immunity in the early development of #zebrafish larvae With @srgouda @Jorges_Lab @ZFINmod
frontiersin.org/articles/10.33…
English
Prabhugouda Siriyappagouder retweetledi

Our new paper on "Differences in the fast muscle methylome provide insight into sex-specific epigenetic regulation of growth in Nile tilapia during the early stages of domestication" is out in Epigenetics tandfonline.com/doi/full/10.10…
English


